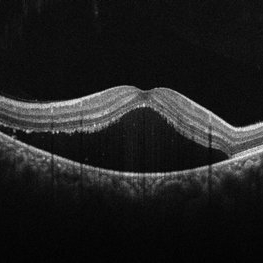

-
 Central Serous Chorioretinopathy
Central Serous Chorioretinopathy
Oct 12 2023 by Akshat Tyagi
Fundus photograph of a 35 year-old man with CSCR and a BCVA of 6/60
Photographer: Akshat Tyagi
Condition/keywords: central serous chorioretinopathy (CSCR)
-
Central Serous Chorioretinopathy
Central Serous Chorioretinopathy
Oct 12 2023 by Akshat Tyagi
OCT Macula of a 35 year-old man with CSCR and a BCVA of 6/60
Photographer: Akshat Tyagi
Condition/keywords: central serous chorioretinopathy (CSCR)
-
 Tractional Retinal Detachment
Tractional Retinal Detachment
May 19 2024 by Akshat Tyagi
Left eye fundus photograph of a 35-year-old woman with tractional retinal detachment as a consequence of Type 1 Diabetes Mellitus.
Photographer: Akshat Tyagi
Imaging device: Huvitz HOCT-1F
Condition/keywords: diabetic blindness, diabetic retinopathy, proliferative diabetic retinopathy (PDR), Retinal Detachment, tractional retinal detachment
-
 Familial Dominant Drusen
Familial Dominant Drusen
May 31 2024 by Akshat Tyagi
OD fundus photograph of a 45-year-old man with multiple drusen distributed all over the posterior pole in both eyes. BCVA was 6/6 OU.
Photographer: Akshat Tyagi
Imaging device: Huvitz HOCT-1
Condition/keywords: Drusen, FAMILIAL DOMINANT DRUSEN
-
 Multiple Lattice Degeneration
Multiple Lattice Degeneration
Dec 31 2025 by Akshat Tyagi
Right Eye UWF of a 29 year old man with multiple lattice degenerations.
Photographer: Akshat Tyagi, Isha Netralaya, Thane
Imaging device: Optos Daytona Plus
Condition/keywords: lattice degeneration
-
 Multiple Lattice Degeneration
Multiple Lattice Degeneration
Dec 31 2025 by Akshat Tyagi
Left eye UWF of a 29 year old man with multiple lattice degeneration.
Photographer: Akshat Tyagi, Isha Netralaya, Thane
Imaging device: Optos Daytona Plus
Condition/keywords: lattice degeneration

A project from the American Society of Retina Specialists